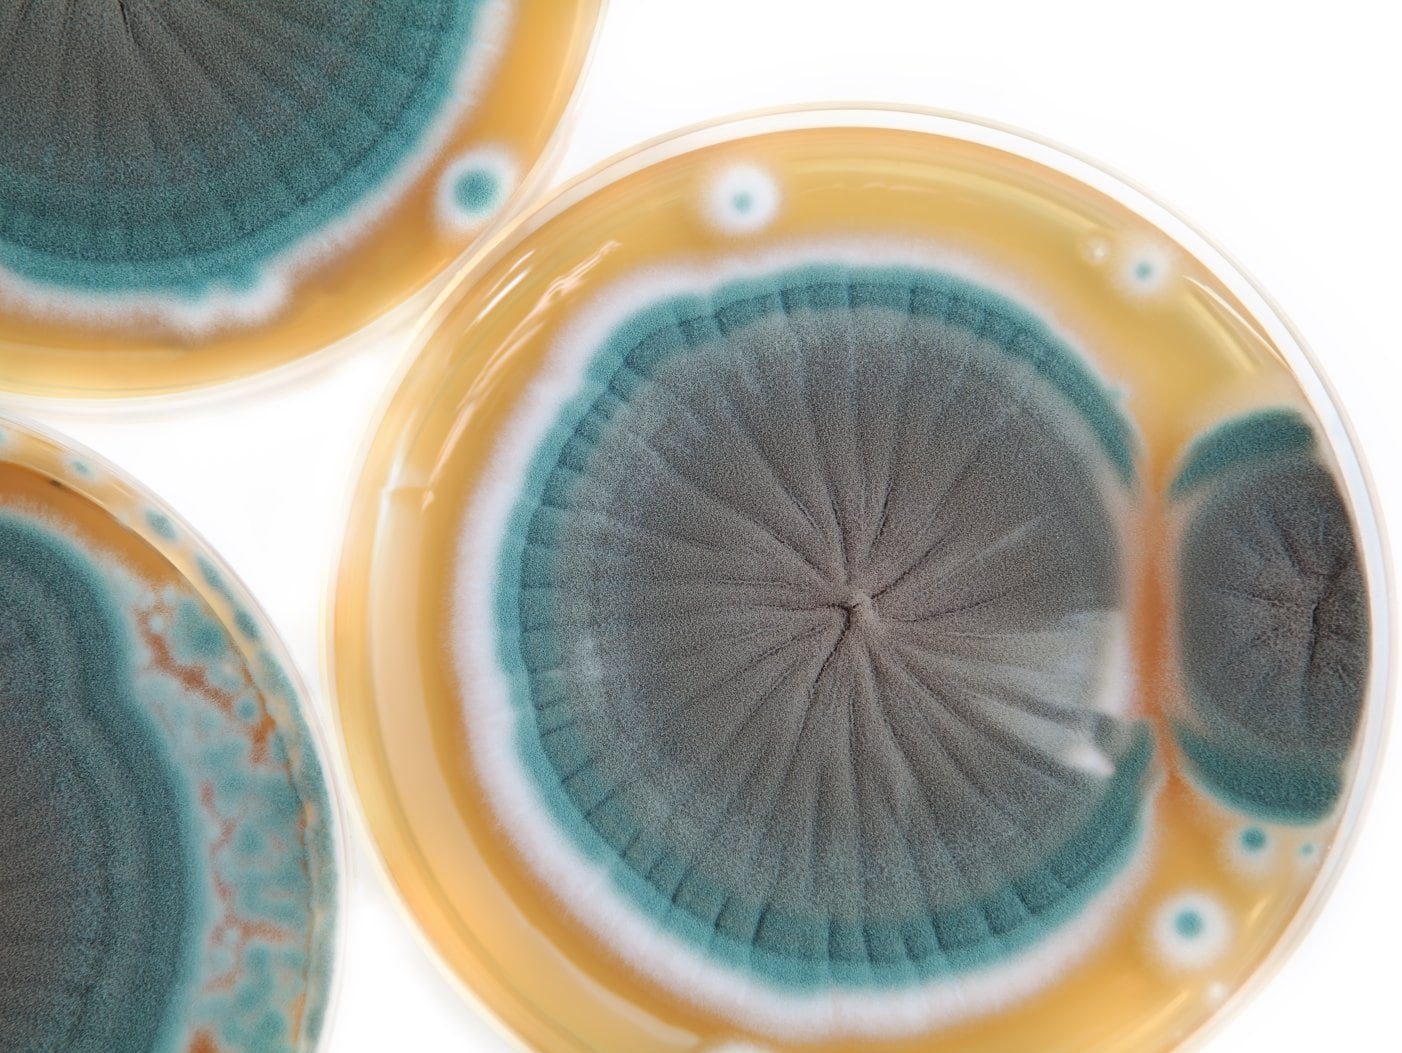
ペニシリン

疫病の歴史・梅毒
前回に引き続き、人類と疫病の歴史について紹介していきます。
今回取り上げるのは
「梅毒」
です。

■代表的な性病
梅毒(Syphilis)は、梅毒トレポネーマ (Treponema pallidum) によって発生する感染症で、
主な感染経路が性行為であるため代表的な性病の一つとして知られています。
ほかに感染者に使った注射器で誤って傷つけてしまう事故、母胎から胎盤を介した感染、薬物の回し打ちなどが感染の原因となっています。
実は梅毒は未だに完全撲滅されていない疫病なのです。
もちろん有効な抗生物質は存在します。
世界初の抗生物質であるペニシリンが開発された1940年代以降、梅毒の発症は大幅に減少。

が、発症の前段階の感染で言うと、発展途上国を中心に今なお増えている状況です。
一般的に病気は一度かかると体内で免疫が形成されるのですが、梅毒に関しては免疫が得られないという特殊な性質を持っています。
ですからたとえ治癒されたとしても再び感染して発症しますし、免疫が形成されないため有効なワクチンも開発できないようです。
■死に至る4段階
梅毒は感染から経過した時間、症状によって4段階に分けられます。
◯第1段階
感染後3週間ぐらいで、粘膜や皮膚に痛みのない小さなしこりができ、何日かするとその中心に硬性下疳(こうせいげかん)と呼ばれる潰瘍ができ、感染部位の近くのリンパ節が腫れます。
◯第2段階
感染後3カ月ぐらいすると、血流に乗って梅毒トレポネーマが全身に広がり、全身の皮膚に淡く赤い発疹が多数できます。

これを梅毒性バラ疹と呼びます。
◯潜伏期
第2段階後、数ヶ月すると症状が一旦消えます。ただしこれは感染が治ったわけではなく、感染したまま潜伏期に入っただけです。
潜伏期が始まってからの2~3年は、第2段階の症状が再発する場合があります。
◯第3段階
感染後にもし治療しなかった場合、3年以上経過すると皮膚、筋肉、骨、内臓にゴムのような腫れ物ができます。

◯第4段階
さらに治療なしで感染から10年ほど経過すると多くの臓器で腫瘍が発生し、加えて脳、脊髄を侵され、死亡します。
今日では医療の発達により第3、第4段階まで進行するのは稀です。
■2つの起源説
梅毒は15世紀末に突如としてヨーロッパを襲い、多くの命をゆっくりと着実に奪いました。
しかし、ヨーロッパでは少なくとも15世紀末より以前は梅毒の蔓延はなく、その症状に当てはまる明確な記録はは見つかっていません。
梅毒の起源については長い間ヨーロッパ起源とアメリカ大陸起源の2つの説が唱えられていました。
前者は古くからヨーロッパに存在していたという主張で、梅毒を示唆していると思われる文書は発見されてはいるものの決定打とはならず、また15世紀よりも古い梅毒患者の人骨の出土もないようです。
仮に15世紀以前に存在していたとしても、症例の少ない珍しい病気だったのではないかと思われます。
後者の説はコロンブスたち冒険者がアメリカ大陸から持ち込んだ病気だという主張です。

初期の航海者が原住民と交渉をもったために梅毒の感染を受け、以後ヨーロッパで蔓延したという。
全米にわたる古代原住民の人骨に関する病理調査でも、梅毒についての物証が得られており、現時点で最も有力な説とされています。
当時スペインの医者。ディアス・デ・イスラの本によると
「この病気は、コロンブス一行が第一回の航海のさい、イスパニョーラ島からもち帰ったものである。
この島のインディアンの間では昔からこの病気があり、コロンブス一行の船員が上陸したとき、この風土病にかかり、病気をもったまま帰航した」
とあります。
ちなみに日本でもコロンブス以前の人骨には梅毒による病変が見つかっていません。

■神の罰と恐れられた病
梅毒がヨーロッパで大流行した際、当たり前ですが現代のような科学に基づく医学的知見はなかったので、
梅毒の正体や感染経路、さらに第3段階の症状と第1、2段階の発疹が同一の病気であることも理解されていませんでした。
神学者たちは梅毒は神によって下された天罰であると唱えました。
医者もいることにはいたのですが、療法と言えば水銀から作った薬を塗る、水銀で体ごと蒸す「水銀風呂」といった、今の常識では到底考えられないような処置でした。

ご存知の通り水銀は猛毒です。多くの人が療法中に水銀中毒を起こして死んでいきました。
もう一つ療法としてもてはやされたのは「癒摘木」という、聖なるインドの樹を使った処方でした。
おそらく何かのハーブだと思うのですが、これが大量にヨーロッパに輸入されました。
この商売で財を成したのがヨーロッパで最も繁栄したフッガー家で、後に宗教改革のきっかけにもなった免罪符にも深く関係した一族です。
そして忌むべき病気であったはずの梅毒が、やがて王族、貴族、司祭階級の間で流行るようになると、
特にフランス、イギリス、スペインの宮廷では梅毒にかかるのはむしろ良い事だと見る風潮が生まれるようになり、
「梅毒にかからないのは教養が足りない証拠だ」
「この病気のない貴族は下等で田舎臭い奴」
とまで言われるようになったとか。
いつの時代も人は自分の都合に合わせて現実を解釈するものかもしれませんね。
この時代、パリでは住民の3分の1が感染したと言われ、有名どこだとフランス王フランソワ一世、イギリス王ヘンリー八世など、多くの人が感染しています。
日本へは1512年に記録上に初めて登場しており、加藤清正、結城秀康(徳川家康の次男)、
大谷吉隆、前田利長(前田利家の長男)、浅野幸長など、名だたる武将が梅毒で死亡したとみられています。
また江戸の庶民への梅毒感染率は50%に達していたという説もあります。
■ペニシリン開発の歴史
梅毒に有効なペニシリンは1928年、イギリスの細菌学者であり、後年ノーベル生理学医学賞を受賞したアレクサンダー・フレミングによってアオカビから発見されました。

「ペニシリン」という名前もアオカビの学名に由来します。
第二次世界大戦中に多くの負傷兵や戦傷者を感染症から救った抗生物質として有名はペニシリンには細菌の細胞壁の合成を阻害する作用があり、これによって抗菌作用を発揮します。
一口にペニシリンといっても、ターゲットとする症状(肺炎、梅毒、咽頭炎、中耳炎、副鼻腔炎、
心内膜炎、筋膜炎など)によって幾つもの種類が開発されており、それらを総称して「ペニシリン系抗生物質」という言い方をします。
血液感染症、皮膚感染症、呼吸器感染症、耳鼻科感染症といった広い範囲の感染症をカバーしているペニシリンは、最も人類を感染病から救ったメジャーな抗生物質です。
ペニシリンは以後の抗生物質の研究開発の契機にもなり、しばしば
「20世紀における偉大な発見」
の一つと称されています。
菌を殺すために、菌を利用する。
まさに毒を以て毒を制すですね。
以上、大禅ビル(福岡市 舞鶴 賃貸オフィス)からでした。
